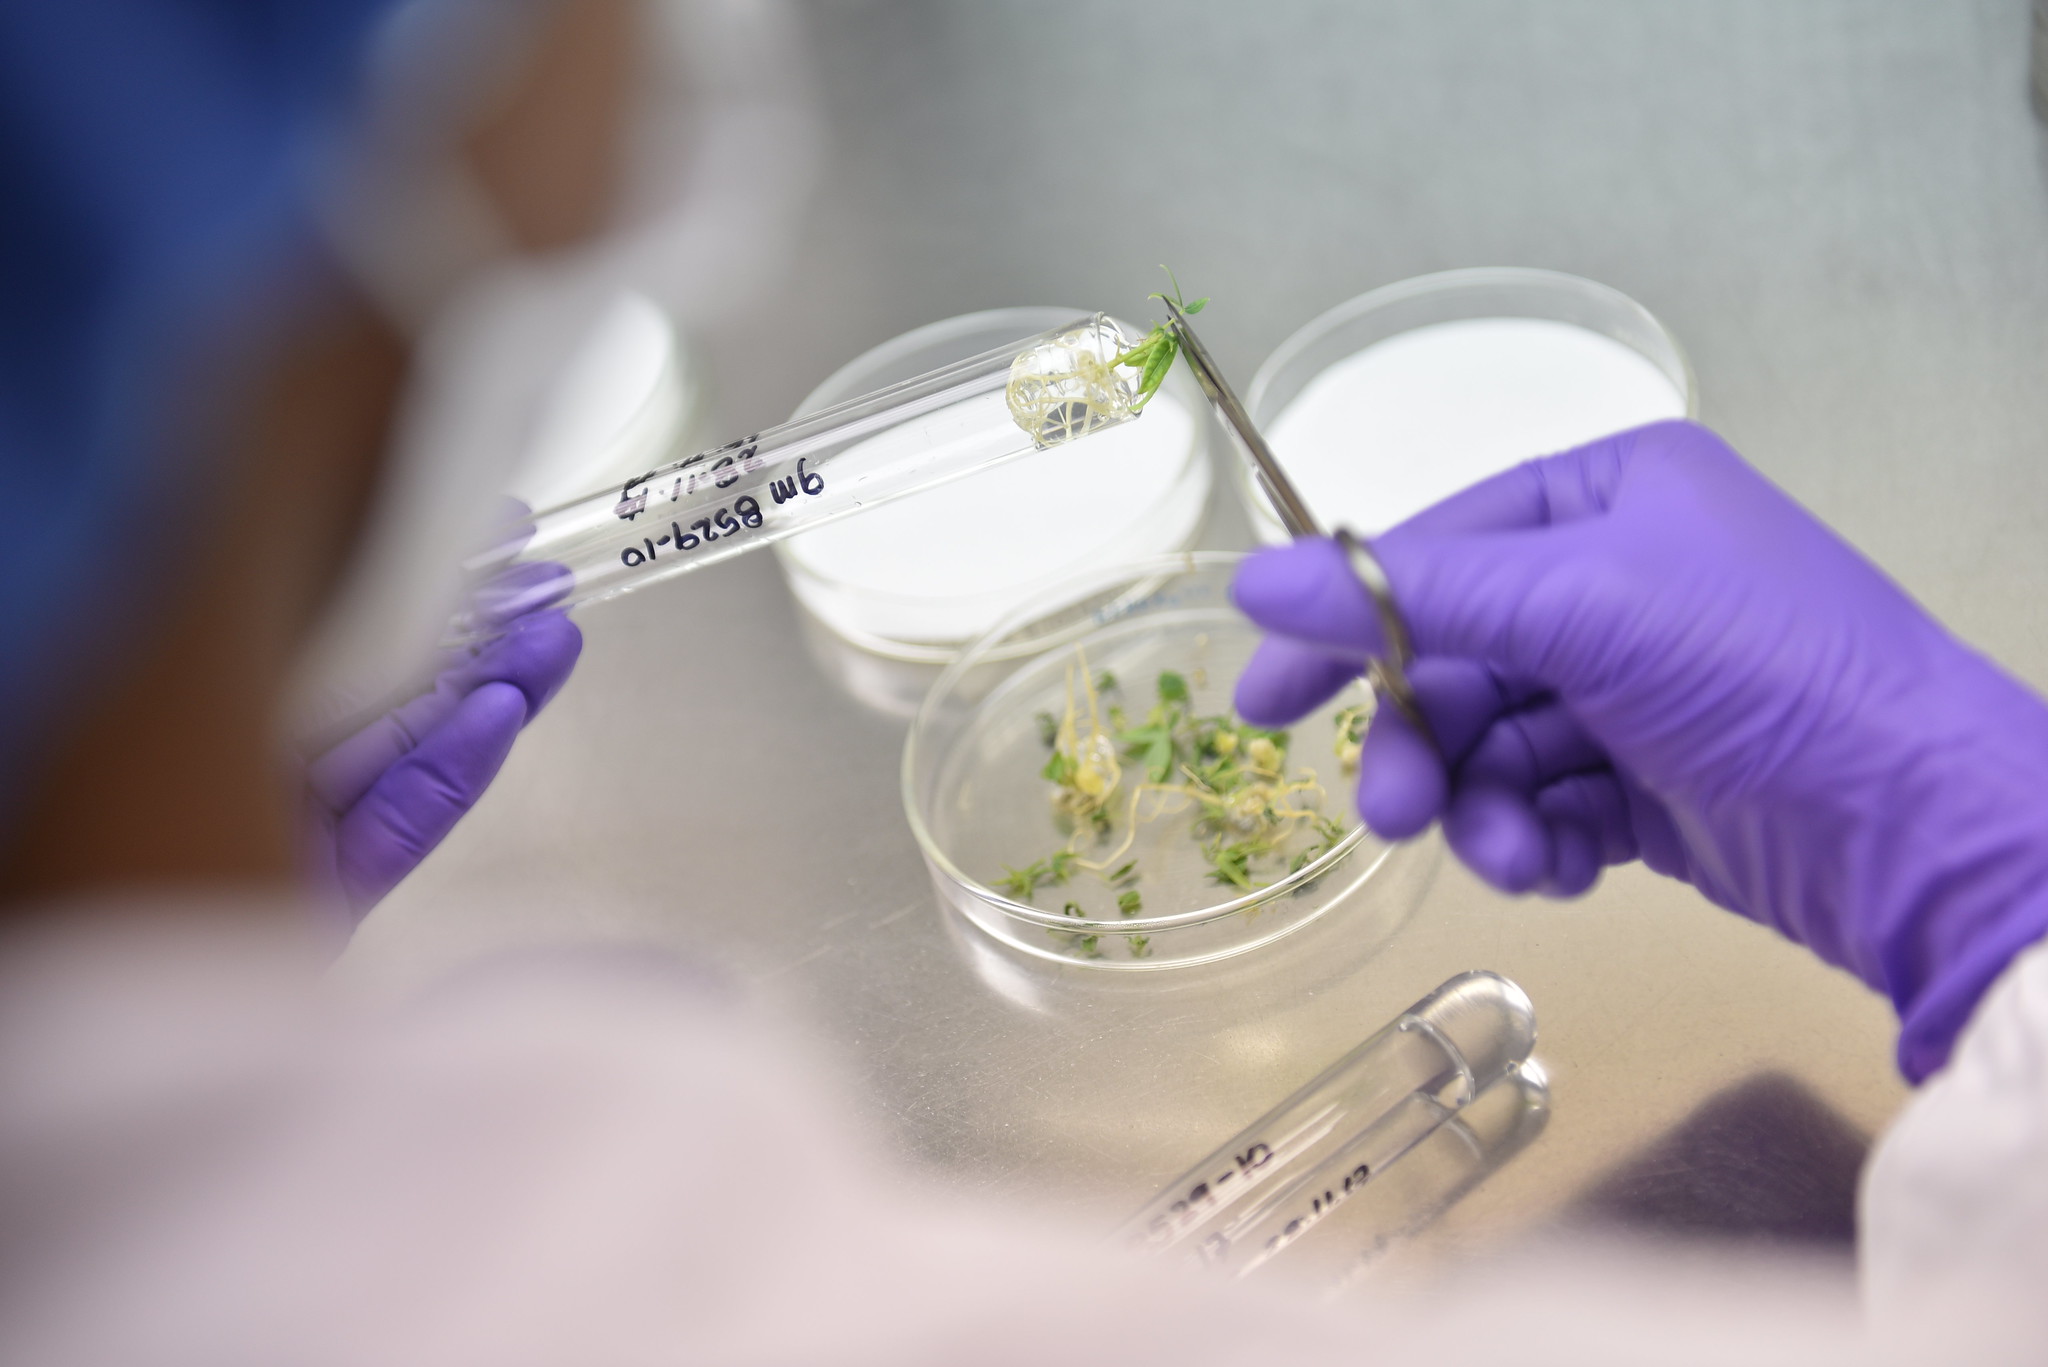

Agronomic approaches for enhancing nutritional value in food crops

Enhancing the nutritional value of food crops plays a critical role in addressing global micronutrient deficiencies. Strategies such as biofortification, crop breeding, and agronomic practices can improve nutrient content in staple foods. Plant physiology—particularly root architecture, nutrient uptake, and transport—affects the accumulation of essential vitamins and minerals while agronomic techniques like balanced fertilization, foliar sprays, soil health management, organic amendments, and precision agriculture can rapidly and practically increase crop nutritional quality. Ultimately, integrating these approaches offers scalable solutions to combat hidden hunger, improve human health, and support sustainable, resilient farming systems worldwide.
Adequate nutrition is fundamental for human growth, development, and health. The major human nutrients include essential amino acids; fatty acids; vitamins; major minerals like calcium, phosphorus, magnesium, sodium, and potassium; trace minerals like iron, zinc, copper, and iodine; and other essential compounds. Adequate nutrition supplies the macronutrients and essential micronutrients that build and maintain tissues, enabling normal growth, development, and physiological function (Savarino et al., 2021). Nutrients also shape disease resistance. Multiple vitamins and minerals (notably vitamins C and D and zinc) support innate and adaptive immune defenses, and even marginal deficiencies can impair immune function (Gombart et al., 2020).
While the world has made significant strides in reducing hunger with global rates down 13%, a less visible but equally serious problem persists (UNICEF, WHO & World Bank, 2023). Billions of people now suffer from "hidden hunger" where diets contain enough calories but lack essential vitamins and minerals. This nutritional crisis affects roughly one-third of the world's population, impacting far more people than the 735–795 million who face actual food scarcity each day (FAO et al., 2023).
The scope of malnutrition is striking: 2.5 billion adults are overweight and 890 million live with obesity while 390 million remain underweight (WHO, 2024). Beyond the human cost, this crisis carries an enormous economic burden with undernutrition and micronutrient deficiencies causing approximately $1 trillion in annual productivity losses worldwide (FAO, 2013).
Micronutrient deficiencies represent one of today's most widespread public health challenges. The most critical shortfalls involve vitamin A, vitamin D, vitamin B12, iron, iodine, and zinc (Weffort et al., 2024). Recent research reveals that more than half of the global population consumes inadequate levels of essential micronutrients, including calcium, iron, and key vitamins (Passarelli et al., 2024). Deficiencies in iron, zinc, and vitamin A weaken immune systems, reduce productivity, and increase mortality rates (Bailey et al., 2015). In the United States alone, one in four pregnant women suffer from iron deficiency while more than half of children under five worldwide lack sufficient vitamins and minerals (CDC, 2025). The situation in low- and middle-income countries is particularly concerning, as over half of adolescent girls and young women do not meet their basic micronutrient requirements (UNICEF, 2021).
Given the scale of the global nutritional crisis, enhancing the nutritional value of food crops presents a promising and scalable solution. While no single food can provide complete nutrition, strategically improving the nutrient profiles of widely consumed crops can help bridge critical dietary gaps worldwide.
Introduction to nutritional enhancement
Nutritional enhancement refers to a set of strategies designed to improve the nutrient content of food crops by increasing essential macro- and micronutrients while minimizing anti-nutritional factors. Improving the nutritional quality of staple crops, as well as other commonly consumed foods, is a critical step toward addressing widespread nutritional deficiencies in the United States and globally. Multiple approaches such as biofortification, genetic improvement, agronomic practices, and post-harvest processing can be employed to achieve sustainable enhancement of food crop nutrition.
Biofortification refers to nutritional enhancement, particularly focusing on micronutrients such as minerals and vitamins (Bouis et al., 2024). One of the most important biofortification programs, HarvestPlus, is run by the CGIAR institute, which works on the development, testing, and scaling of biofortified varieties of 12 staple crops, thereby improving the diets of hundreds of millions of people (Figure 1). The HarvestPlus program targets key micronutrients by developing vitamin A-rich sweet potato, maize, and cassava; iron-rich beans and pearl millet; and zinc-rich rice and wheat (Van Der Straeten et al., 2020). By 2022, it had officially released more than 445 biofortified crop varieties across 40 countries, reaching over 100 million people and improving nutritional status, especially among women and children (Bouis et al., 2024).

Physiological insights for improving nutritional value in food crops
Enhancing nutrition in food crops requires understanding how plants acquire and distribute nutrients through three critical stages: (i) mineral and water uptake by roots (ii) long-distance transport via xylem and phloem, and (iii) targeted delivery to specific plant organs.
Root architecture plays a fundamental role in nutrient uptake capacity. Variations in root systems significantly influence concentrations of zinc, iron, protein, and other nutrients in grains and fruits (Noor et al., 2024; Amiri et al., 2015; Sultana et al., 2023). Robust root systems provide a larger area for nutrient uptake and mobilization. For instance, wild germplasms such as Triticum polonicum with robust root systems have been identified as a valuable breeding source for enhancing essential minerals such as copper, magnesium, selenium, and zinc (Bieńkowska et al., 2019). Furthermore, these germplasms also contain higher amounts of phenolics, flavonoids, and carotenoids in the grain, the traits which could be transferred to elite wheat cultivars for enhancing nutritional quality (Suchowilska et al., 2020).

Additionally, improved root traits such as larger xylem vessels and phloem parenchyma in roots have also been associated with higher mineral and antioxidant content in various plants, from grapes to carrots (Klimek et al., 2022; Zhao et al., 2025). Moreover, root stocks have also been an important source for enhancing the phenolic compounds and antioxidants as well as fruit quality in grapes (Ozden et al., 2010; Cheng et al., 2017). These findings demonstrate that root system architecture can be targeted traits for enhancing nutritional value in food crops.
Once absorbed, nutrients are transported throughout the plants through the vascular tissues, xylem and phloem. The efficient long-distance transport in vascular tissues strongly influences the mineral content in grains and fruits (Braun et al., 2014). Further, the micronutrients are transferred to the seeds through sieve elements via plasmodesmata (Patrick & Offler, 2001). For example, iron is accumulated into wheat grains through phloem transport (Garnett & Graham, 2005; Grillet et al., 2014).
Mineral uptake and distribution are controlled by ion channels and membrane transport proteins in root and shoot tissues. The key transporter families for increasing the micronutrient content in plant tissues include ZIP proteins for zinc and iron transport, NRAMP proteins for divalent metals transport, and HMA proteins for metal efflux (Hussain et al., 2004; Nevo & Nelson, 2006; Ajeesh Krishna et al., 2020). Modifying these transport systems through breeding or genetic engineering represents a promising strategy to improve micronutrient content in grains and fruits. For example, overexpression of ZIP transporters enhances zinc accumulation in rice and wheat, demonstrating the potential of transporter-based biofortification (Lee et al., 2010; Li et al., 2021).
Approaches for improving nutritional value in food crops
There are several ways to improve the nutritional value of food crops. These strategies span agronomic management practices, crop breeding, and genetic engineering with the choice of approach depending on the crop species, target nutrients, and prevailing environmental and soil conditions (Bouis & Saltzman, 2017; Garg et al., 2018). For farmers, crops must not only be nutrient rich but also high yielding and tolerant to various biotic and abiotic stresses. Therefore, while enhancing nutritional value, it is equally important to consider these other factors to ensure that farmers can readily adopt new varieties and technologies.
Conventional breeding provides a cost-effective, sustainable, and long-term strategy for improving the nutritional value of crops by developing varieties with higher concentrations of essential minerals and nutrients. However, this approach is often time-consuming, and its effectiveness is strongly influenced by environmental conditions and the genetic background of the crop.
Transgenic approaches offer an alternative, particularly when natural genetic variation for specific nutrients is limited or absent within a species. These methods enable the introduction of beneficial genes from other species or the precise editing of target genes to enhance nutrient content, improve bioavailability, and reduce antinutritional compounds.
In contrast, agronomic approaches represent practical and relatively rapid strategies, relying on optimized fertilizer application rates, timing, and methods. Techniques such as soil application, foliar spraying, nutri-priming, and hydroponic cultivation are commonly employed. While these methods can be applied broadly across crop species and are generally less resource and time intensive than breeding-based approaches, their effectiveness remains sensitive to environmental conditions, and careful management is required to minimize nutrient losses and environmental risks.
Agronomic approaches for improving nutritional value
Agronomic practices are central to improving the nutritional value of food crops and addressing micronutrient deficiencies in human diets. While plant nutrition management has traditionally prioritized yield, growing evidence also shows that integrated management of macro- and micronutrients can increase the nutrient density of harvested grains. Key approaches include fertilizer management, soil and rhizosphere optimization, foliar nutrient application, precision agriculture, and integrated crop management.
Fertilizer management

Fertilizer management (Figure 2) is a key agronomic approach for enhancing the nutritional value of food crops. While macronutrients such as nitrogen, phosphorus and potassium are primarily applied to improved yield, their balanced use also influences the uptake and partitioning of micronutrients.
Nitrogen, essential for photosynthesis and protein synthesis, indirectly enhances grain zinc and iron concentrations by stimulating root growth, delaying senescence, and extending grain filling in wheat (Figure 3) (Miner et al., 2022).
Phosphorus fertilization contributes to nutritional quality by improving root growth and enhancing the mobility of zinc and iron in soils, which supports their uptake and accumulation in grains. Adequate phosphorus supply has been associated with higher grain zinc concentrations in maize and wheat grown on phosphorus -deficient soils (Zhang et al., 2012; Sánchez-Rodríguez et al., 2021).

Potassium, in turn, plays a critical role in carbohydrate transport and enzyme activation, indirectly supporting micronutrient translocation and protein synthesis. Field studies have shown that balanced potassium application improves nitrogen use efficiency and grain protein quality, while also enhancing micronutrient accumulation in cereals (Guo et al., 2019; Römheld & Kirkby, 2010).
Direct micronutrient fertilization is often necessary to achieve substantial improvements in grain nutrient content. For instance, soil- or foliar-applied zinc has consistently increased seed zinc concentrations in soybean and maize, even without yield gains, demonstrating that nutritional quality can be enhanced independently of productivity (Lamb & Nelson, 2015). In contrast, iron fertilization has produced mixed outcomes. Studies in Kansas and the U.S. Central Great Plains found that foliar iron applications in soybean occasionally reduced yield due to leaf injury while in wheat, higher yields were frequently associated with lower grain iron, a phenomenon known as the “dilution effect” (Ruiz Diaz, 2013; Miner et al., 2022). These findings indicate that iron enrichment requires integrated fertility management and careful consideration of soil health, crop types, and nutrient interactions.
Soil and rhizosphere
Understanding soil and rhizosphere interactions is essential for maintaining soil health, optimizing nutrient recycling and soil management, and ultimately helping with nutrient bioavailability and uptake in plants (Ghimire et al., 2024). The physical, chemical, and biological properties of soil determine its fertility and nutrient availability. Soil physical characteristics, such as texture, particle size, and mineral composition, determine nutrient retention and exchange. Soils rich in clay and organic matter generally hold more positively charged nutrients, such as potassium, calcium, and magnesium (Mengel et al., 2001).
Soil texture and porosity influence the movement of nutrients toward the root surface. Mobile ions such as nitrate, sulfate, chloride, and boric acid are transported mainly by mass flow, whereas diffusion is the predominant pathway for less mobile nutrients such as phosphorus and often potassium (Halvin et al., 2005). Furthermore, the acidity and alkalinity of soil regulate nutrient uptake. For example, acidic soils limit the uptake of phosphorus, calcium, and magnesium while alkaline soils restrict iron, zinc, and manganese uptake (Marschner, 2011).
Applications of arbuscular mycorrhizal fungi and plant growth-promoting bacteria increase the rhizosphere microbiome and nutritional bioavailability and uptake, which can lead to high nutritional quality. Several studies have shown that inoculation of arbuscular mycorrhizal fungi and plant growth-promoting bacteria increase the content of vitamins, various organic acids, and overall fruit quality of strawberry and tomato (Bona et al., 2015, 2017).

Organic amendments such as animal manure, green manures, mulches, and cover crops have shown strong potential to improve the nutritional value of crops. For instance, Hunter et al (2011) reported the higher level of micronutrient composition in plant foods grown using organic agricultural methods than those using conventional methods. A recent review found that the use of these organic inputs led to significant increases in iron and zinc concentrations in grains in maize (Manzeke-Kangara et al., 2023). Different mulching practices have also been reported to increase the fruit and nutritional quality in strawberries (Atkinson et al., 2006). Biochar has also been getting a lot of attention among farmers as it increases the yield and nutritional quality of crops (Lei et al., 2024). This shows that organic amendment is a promising tool for increasing the nutritional value of food crops.
Furthermore, the National Academies of Sciences, Engineering, and Medicine (2024) has also prioritized the exploration of linkages between soil health and human health, promoting research on microbial communities for soil health, food quality, and human health.
Foliar sprays
Foliar fertilization is an effective nutrient management strategy where dose, timing, and crop stage are critical for optimal uptake (Fernandez & Eichert, 2009). In situations where soil conditions restrict nutrient availability or when tissue analysis or visual symptoms indicate deficiencies, foliar fertilization can be used to supply essential nutrients (Rajasekar et al., 2017). It is particularly valuable for micronutrients due to efficient leaf absorption and is useful when soil constraints like high pH or excess moisture limit root uptake.
The effectiveness of foliar fertilization depends on proper timing relative to environmental conditions, crop growth stage, and overall plant health. Applications are most efficient during early morning or late afternoon when cooler temperatures and moderate humidity enhance leaf permeability and nutrient absorption (Oosterhuis, 2009). Foliar sprays are particularly effective for enhancing nutritional quality when aligned with critical growth stages such as grain filling and fruit development (Jalal et al., 2023). For instance, foliar application of nitrogen increases grain protein content in wheat (Turley et al., 2001; Dick et al., 2016).
Jalali et al (2022) reported that the foliar spray of biostimulants like seaweed extract mixed with micronutrients increases nutritional quality and yield of tomato. Several studies have been conducted on foliar applications of micronutrients like iodine, silicon, zinc, and iron which result in increasing their concentration in grains and fruits (Budke et al., 2021; Hao et al., 2021; Lu et al., 2024). Thus, foliar application of micronutrients and bio stimulants hold a promising role for increasing nutritional quality of food crops.
Precision agriculture
With the development of precision agriculture tools, sensors, drones, and decision support systems have been used in nutrition management as well as crop management in agriculture. Identifying the moisture stress and deficiency of different macro- and micronutrients through drone and remote sensing tools can help in precise irrigation and application of nutrients, thus ensuring proper uptake of water and nutrients, especially during grain filling and fruit development.

Water management is a key factor in optimizing the yield and quality. Soil moisture sensors provide continuous measurements of root zone water status, which is directly linked to crop productivity (Cominelli et al., 2024). Their use in tomato production increases both yield and fruit quality through better understanding of precise water requirements (El Chami et al., 2023; He et al., 2024). Similarly, sensor-based irrigation management in grapevines improves fruit quality while conserving water (Garofalo et al., 2023). Furthermore, multispectral and thermal remote sensing help determine water requirements at critical growth stages, improving grapefruit quality (Bellvert et al., 2016; Jewan et al., 2024).
Precision agriculture also facilitates nutrient optimization (Figure 4) by improving timing, placement, and application rates based on real-time field data. Decision-support platforms integrate sensor information, yield maps, and crop models to guide management practices that enhance both productivity and nutritional quality (Gebbers & Adamchuk, 2010; Xing & Wang, 2024). Combined with precision irrigation, these tools enable synchronized nutrient and water management, enhancing uptake efficiency during critical growth stages. Unmanned aerial vehicles (UAV) provide an effective delivery method for nutrients and biostimulants. For example, Xu et al. (2021) reported that UAV-applied chelated zinc fertilizers increased the zinc content in rice grains while offering a safe, effective, and economical application method.
Conclusion and future perspectives
Enhancing the nutritional value of food crops is central to addressing hidden hunger and improving global health. Successful nutritional improvement of food crops requires an integrated understanding of plant physiology, from root architecture and nutrient uptake to vascular transport and grain-loading mechanisms. The synergistic application of agronomic approaches, including precision fertilizer management, soil health optimization, foliar applications, and precision agriculture technologies, offers immediate and scalable solutions that improve food quality while supporting resilient, sustainable farming systems benefitting producers and consumers.
Future research should prioritize the development of smart delivery systems that combine real-time nutrient sensing in soil and plants with targeted application technologies and digital agriculture. Exploring the soil–plant–human health continuum through interdisciplinary approaches will be essential for developing sustainable nutritional enhancement strategies. Scaling innovations across diverse environments, while ensuring farmer adoption and affordability, remains critical. Ultimately, linking soil health, crop nutrition, and human well-being provides a transformative opportunity to reduce nutritional crisis and strengthen food system resilience worldwide. Achieving this goal requires substantial investment and long-term commitment from governments and funding bodies, particularly given that nutritional enhancement is influenced by diverse environmental factors.
Ajeesh Krishna, T. P., Maharajan, T., Victor Roch, G., Ignacimuthu, S., & Antony Ceasar, S. (2020). Structure, function, regulation and phylogenetic relationship of ZIP family transporters of plants. Frontiers in Plant Science, 11, 662.
Amiri, R., Bahraminejad, S., Sasani, S., Jalali-Honarmand, S., & Fakhri, R. (2015). Bread wheat genetic variation for grain’s protein, iron and zinc concentrations as uptake by their genetic ability. European Journal of Agronomy, 67, 20–26.
Atkinson, C. J., Dodds, P. A. A., Ford, Y. Y., Le Mière, J., Taylor, J. M., Blake, P. S., & Paul, N. (2006). Effects of cultivar, fruit number and reflected photosynthetically active radiation on Fragaria × ananassa productivity and fruit ellagic acid and ascorbic acid concentrations. Annals of Botany, 97(3), 429–441.
Bailey, R. L., West, K. P., & Black, R. E. (2015). The epidemiology of global micronutrient deficiencies. Annals of Nutrition and Metabolism, 66(Suppl. 2), 22–33. https://doi.org/10.1159/000371618
Bellvert, J., Zarco-Tejada, P. J., Marsal, J., Girona, J., González-Dugo, V., & Fereres, E. (2016). Vineyard irrigation scheduling based on airborne thermal imagery and water potential thresholds. Australian Journal of Grape and Wine Research, 22(2), 307–315.
Bieńkowska, T., Suchowilska, E., Kandler, W., Krska, R., & Wiwart, M. (2019). Triticum polonicum L. as potential source material for the biofortification of wheat with essential micronutrients. Plant Genetic Resources, 17(3), 213–220.
Bona, E., Cantamessa, S., Massa, N., Manassero, P., Marsano, F., Copetta, A., … & Berta, G. (2017). Arbuscular mycorrhizal fungi and plant growth-promoting pseudomonads improve yield, quality and nutritional value of tomato: a field study. Mycorrhiza, 27(1), 1–11.
Bona, E., Lingua, G., Manassero, P., Cantamessa, S., Marsano, F., Todeschini, V., … & Berta, G. (2015). AM fungi and PGP pseudomonads increase flowering, fruit production, and vitamin content in strawberry grown at low nitrogen and phosphorus levels. Mycorrhiza, 25(3), 181–193.
Bouis, H. E., & Saltzman, A. (2017). Improving nutrition through biofortification: a review of evidence from HarvestPlus, 2003 through 2016. Global Food Security, 12, 49–58.
Bouis, H., Foley, J., Lividini, K., Jumrani, J., Reinke, R., Van Der Straeten, D., Zagado, R., Boy, E., Brown, L. R., Mudyahoto, B., Alioma, R., Hussain, M., & Pfeiffer, W. H. (2024). Biofortification: Future challenges for a newly emerging technology to improve nutrition security sustainably. Current Developments in Nutrition, 8(12), 104478. https://doi.org/10.1016/j.cdnut.2024.104478
Braun, D. M., Wang, L., & Ruan, Y. L. (2014). Understanding and manipulating sucrose phloem loading, unloading, metabolism, and signalling to enhance crop yield and food security. Journal of Experimental Botany, 65(7), 1713–1735.
Budke, C., Dierend, W., Schön, H. G., Hora, K., Mühling, K. H., & Daum, D. (2021). Iodine biofortification of apples and pears in an orchard using foliar sprays of different composition. Frontiers in Plant Science, 12, 638671.
Centers for Disease Control and Prevention. (2025). Micronutrients. https://www.cdc.gov/nutrition/php/micronutrients/index.html
Cheng, J., Wei, L., Mei, J., & Wu, J. (2017). Effect of rootstock on phenolic compounds and antioxidant properties in berries of grape (Vitis vinifera L.) cv. ‘Red Alexandria’. Scientia Horticulturae, 217, 137–144.
Cominelli, S., Rivera, L. D., Brown, W. G., Ochsner, T. E., & Patrignani, A. (2024). Calibration of TEROS 10 and TEROS 12 electromagnetic soil moisture sensors. Soil Science Society of America Journal, 88(6), 2104–2122. https://doi.org/10.1002/saj2.20777
Dick, C. D., Thompson, N. M., Epplin, F. M., & Arnall, D. B. (2016). Managing late-season foliar nitrogen fertilization to increase grain protein for winter wheat. Agronomy Journal, 108(6), 2329–2338.
El Chami, A., Cortignani, R., Dell’Unto, D., Mariotti, R., Santelli, P., Ruggeri, R., … & Cardarelli, M. (2023). Optimization of applied irrigation water for high marketable yield, fruit quality and economic benefits of processing tomato using a low-cost wireless sensor. Horticulturae, 9(3), 390.
FAO, IFAD, UNICEF, WFP, & WHO. (2023). The State of Food Security and Nutrition in the World 2023: Urbanization, agrifood systems transformation and healthy diets across the rural–urban continuum. FAO. https://doi.org/10.4060/cc3017en
Food and Agriculture Organization. (2013). State of food and agriculture 2013: Food systems for better nutrition (ESA/FAO).
Fernández, V., & Eichert, T. (2009). Uptake of hydrophilic solutes through plant leaves: current state of knowledge and perspectives of foliar fertilization. Critical Reviews in Plant Sciences, 28(1–2), 36–68. https://doi.org/10.1080/07352680902743069
Garg, M., Sharma, N., Sharma, S., Kapoor, P., Kumar, A., Chunduri, V., & Arora, P. (2018). Biofortified crops generated by breeding, agronomy, and transgenic approaches are improving lives of millions of people around the world. Frontiers in Nutrition, 5, 12.
Garnett, T. P., & Graham, R. D. (2005). Distribution and remobilization of iron and copper in wheat. Annals of Botany, 95(5), 817–826.
Garofalo, S. P., Intrigliolo, D. S., Camposeo, S., Alhajj Ali, S., Tedone, L., Lopriore, G., … & Vivaldi, G. A. (2023). Agronomic responses of grapevines to an irrigation scheduling approach based on continuous monitoring of soil water content. Agronomy, 13(11), 2821.
Gebbers, R., & Adamchuk, V. I. (2010). Precision agriculture and food security. Science, 327(5967), 828–831.
Ghimire, O. P., Lazo, A., Parajuli, B., & Nepal, J. (2024). Fostering microbial activity and diversity in agricultural systems: adopting better management practices and strategies: Part 1. CSA News, 69(6), 43–47.
Gombart, A. F., Pierre, A., & Maggini, S. (2020). A review of micronutrients and the immune system – working in harmony to reduce the risk of infection. Nutrients, 12(1), 236.
Grillet, L., Mari, S., & Schmidt, W. (2014). Iron in seeds – loading pathways and subcellular localization. Frontiers in Plant Science, 4, 535.
Guo, J., Jia, Y., Chen, H., Zhang, L., Yang, J., Zhang, J., & Hu, X. (2019). Growth, photosynthesis, and nutrient uptake in wheat are affected by N forms and potassium supply. Scientific Reports, 9, 12401. https://doi.org/10.1038/s41598-018-37838-3
Halvin, J. L., Beaton, J. D., Tisdale, S. L., & Nelson, W. L. (2005). Soil fertility and fertilizers: an introduction to nutrient management. Prentice Hall.
Hao, B., Ma, J., Jiang, L., Wang, X., Bai, Y., Zhou, C., … & Wang, Z. (2021). Effects of foliar application of micronutrients on concentration and bioavailability of zinc and iron in wheat landraces and cultivars. Scientific Reports, 11(1), 22782.
He, Y., Wang, J., Yang, J., Bai, P., Feng, J., Wu, Y., … & Liao, W. (2024). Enhancement of tomato fruit quality through moderate water deficit. Foods, 13(22), 3540.
Hunter, D., Foster, M., McArthur, J. O., Ojha, R., Petocz, P., & Samman, S. (2011). Evaluation of the micronutrient composition of plant foods produced by organic and conventional agricultural methods. Critical Reviews in Food Science and Nutrition, 51(6), 571–582.
Hussain, D., Haydon, M. J., Wang, Y., Wong, E., Sherson, S. M., Young, J., … & Cobbett, C. S. (2004). P-type ATPase heavy metal transporters with roles in essential zinc homeostasis in Arabidopsis. The Plant Cell, 16(5), 1327–1339.
Jalal, A., Oliveira, C. E. D. S., Fernandes, G. C., da Silva, E. C., da Costa, K. N., de Souza, J. S., … & Teixeira Filho, M. C. M. (2023). Integrated use of plant growth-promoting bacteria and nano-zinc foliar spray is a sustainable approach for wheat biofortification, yield, and zinc use efficiency. Frontiers in Plant Science, 14, 1146808.
Jalali, P., Roosta, H. R., Khodadadi, M., Torkashvand, A. M., & Jahromi, M. G. (2022). Effects of brown seaweed extract, silicon, and selenium on fruit quality and yield of tomato under different substrates. PLOS ONE, 17(12), e0277923.
Jewan, S. Y. Y., Gautam, D., Sparkes, D., Singh, A., Billa, L., Cogato, A., … & Pagay, V. (2024). Integrating hyperspectral, thermal, and ground data with machine learning algorithms enhances the prediction of grapevine yield and berry composition. Remote Sensing, 16(23), 4539.
Klimek, K., Kapłan, M., & Najda, A. (2022). Influence of rootstock on yield quantity and quality, contents of biologically active compounds and antioxidant activity in Regent grapevine fruit. Molecules, 27(7), 2065.
Lamb, A., & Nelson, N. (2015). Corn response to foliar-applied zinc fertilizers. Kansas Agricultural Experiment Station Research Reports, 1(3). https://doi.org/10.4148/2378-5977.1035
Lee, S., Kim, S. A., Lee, J., Guerinot, M. L., & An, G. (2010). Zinc deficiency-inducible OsZIP8 encodes a plasma membrane-localized zinc transporter in rice. Molecules and Cells, 29(6), 551–558.
Lei, Y., Xu, L., Wang, M., Sun, S., Yang, Y., & Xu, C. (2024). Effects of biochar application on tomato yield and fruit quality: a meta-analysis. Sustainability, 16(15), 6397.
Li, S., Liu, Z., Guo, L., Li, H., Nie, X., Chai, S., & Zheng, W. (2021). Genome-wide identification of wheat ZIP gene family and functional characterization of TaZIP13-B in plants. Frontiers in Plant Science, 12, 748146.
Lu, B., An, H., Song, X., Yang, B., Jian, Z., Cui, F., … & Du, T. (2024). Enhancement of nutritional substance, trace elements, and pigments in waxy maize grains through foliar application of selenite. Foods, 13(9), 1337.
Manzeke-Kangara, M. G., Joy, E. J. M., Lark, R. M., Redfern, S., Eilander, A., & Broadley, M. R. (2023). Do agronomic approaches aligned to regenerative agriculture improve the micronutrient concentrations of edible portions of crops? A scoping review of evidence. Frontiers in Nutrition, 10. https://doi.org/10.3389/fnut.2023.1078667
Marschner, P. (2011). Marschner’s mineral nutrition of higher plants (3rd ed.).
Mengel, K., Kirkby, E. A., Kosegarten, H., & Appel, T. (2001). The soil as a plant nutrient medium. In Principles of plant nutrition (pp. 15–110). Springer Netherlands.
Miner, G. L., Delgado, J. A., Ippolito, J. A., Johnson, J. J., Kluth, D. L., & Stewart, C. E. (2022). Wheat grain micronutrients and relationships with yield and protein in the U.S. Central Great Plains. Field Crops Research, 279, 108453. https://doi.org/10.1016/j.fcr.2022.108453
National Academies of Sciences, Engineering, and Medicine. (2024). Exploring linkages between soil health and human health.
Nevo, Y., & Nelson, N. (2006). The NRAMP family of metal-ion transporters. Biochimica et Biophysica Acta (BBA) – Molecular Cell Research, 1763(7), 609–622.
Noor, M., Kiran, A., Shahbaz, M., Sanaullah, M., & Wakeel, A. (2024). Root system architecture associated zinc variability in wheat (Triticum aestivum L.). Scientific Reports, 14(1), 1781.
Oosterhuis, D. (2009). Foliar fertilization: mechanisms and magnitude of nutrient uptake. In Proceedings of the Fluid Forum (pp. 15–17).
Ozden, M., Vardin, H., Simsek, M., & Karaaslan, M. (2010). Effects of rootstocks and irrigation levels on grape quality of Vitis vinifera L. cv. Shiraz. African Journal of Biotechnology, 9(25), 3801–3807.
Passarelli, S., Free, C. M., Shepon, A., Beal, T., Batis, C., & Golden, C. D. (2024). Global estimation of dietary micronutrient inadequacies: a modelling analysis. The Lancet Global Health, 12(10), e1590–e1599.
Patrick, J. W., & Offler, C. E. (2001). Compartmentation of transport and transfer events in developing seeds. Journal of Experimental Botany, 52(356), 551–564.
Rajasekar, M., Nandhini, D. U., & Suganthi, S. (2017). Supplementation of mineral nutrients through foliar spray – a review. International Journal of Current Microbiology and Applied Sciences, 6(3), 2504–2513.
Römheld, V., & Kirkby, E. A. (2010). Research on potassium in agriculture: Needs and prospects. Plant and Soil, 335(1–2), 155–180. https://doi.org/10.1007/s11104-010-0520-1
Ruiz Diaz, D. (2013). Kansas Pasture Fertilizer Research 2012. Kansas Agricultural Experiment Station Research Reports, 5. https://doi.org/10.4148/2378-5977.3320
Sánchez-Rodríguez, A. R., del Campillo, M. C., Delgado, A., & Torrent, J. (2021). Combining P and Zn fertilization to enhance yield and grain quality in maize grown on Mediterranean soils. Scientific Reports, 11, 7057. https://doi.org/10.1038/s41598-021-86766-2
Savarino, G., Corsello, A., & Corsello, G. (2021). Macronutrient balance and micronutrient amounts through growth and development. Italian Journal of Pediatrics, 47(1), 109.
Suchowilska, E., Bieńkowska, T., Stuper-Szablewska, K., & Wiwart, M. (2020). Concentrations of phenolic acids, flavonoids and carotenoids and the antioxidant activity of the grain, flour and bran of Triticum polonicum as compared with three cultivated wheat species. Agriculture, 10(12), 591.
Sultana, R., Kiran, A., Sanaullah, M., & Wakeel, A. (2023). Exploring the linkage between root system architecture and grain iron content in wheat (Triticum aestivum L.). Frontiers in Sustainable Food Systems, 7, 1156728.
Turley, D. B., Sylvester-Bradley, R., & Dampney, P. M. R. (2001). Foliar-applied nitrogen for grain protein and canopy management of wheat.
UNICEF, WHO, & World Bank. (2023). Joint child malnutrition estimates – 2023 edition. https://data.unicef.org/resources/jme-report-2023/
UNICEF. (2021). Fed to Fail? The crisis of children’s diets in early life.https://www.unicef.org/reports/fed-to-fail
Van Der Straeten, D., Bhullar, N. K., De Steur, H., Gruissem, W., MacKenzie, D., Pfeiffer, W., Qaim, M., Slamet-Loedin, I., Strobbe, S., Tohme, J., Trijatmiko, K. R., Vanderschuren, H., Van Montagu, M., Zhang, C., & Bouis, H. (2020). Multiplying the efficiency and impact of biofortification through metabolic engineering. Nature Communications, 11, 5203. https://doi.org/10.1038/s41467-020-19020-4
Weffort, V. R. S., & Lamounier, J. A. (2024). Hidden hunger – a narrative review. Jornal de Pediatria, 100, S10–S17.
World Health Organization. (2024). Malnutrition [Fact sheet]. https://www.who.int/news-room/fact-sheets/detail/malnutrition
Xing, Y., & Wang, X. (2024). Precision agriculture and water conservation strategies for sustainable crop production in arid regions. Plants, 13(22), 3184.
Xu, M., Liu, M., Liu, F., Zheng, N., Tang, S., Zhou, J., … & Wu, L. (2021). A safe, high fertilizer-efficiency and economical approach based on a low-volume spraying UAV loaded with chelated-zinc fertilizer to produce zinc-biofortified rice grains. Journal of Cleaner Production, 323, 129188.
Zhang, Y., Shi, R., Karim, M. R., Zhang, F., & Zou, C. (2012). How does phosphorus application affect zinc uptake and grain zinc concentration in wheat? Plant and Soil, 361(1–2), 143–152. https://doi.org/10.1007/s11104-012-1238-z
Zhao, Y., Gong, Y., Li, Y., Xin, H., Chi, R., & Chen, Y. (2025). High-quality carrots in relation to the superior phloem parenchyma cells and proportion of xylem vessel in coordinated water-fertilizer management. Frontiers in Plant Science, 16, 1590774.
Graduate Student Committee: Connect with us!
This article is a contribution of the ASA, CSSA, and SSSA Graduate Student Committee. If you would like to provide feedback to this committee on its work or want to volunteer with the committee to help plan any of its activities or write articles like this one, please reach out to Jessica Bezerra de Oliveira, the 2025 Chair of the committee!
If you would like to stay up to date with our committee, learn more about our work, contribute to one of our CSA News articles or suggest activities you would like us to promote, watch your emails, connect with us on X or visit: agronomy.org/membership/committees/view/ACS238/members, crops.org/membership/committees/view/ACS238/members, or soils.org/membership/committees/view/ACS238/members.
Text © . The authors. CC BY-NC-ND 4.0. Except where otherwise noted, images are subject to copyright. Any reuse without express permission from the copyright owner is prohibited.









